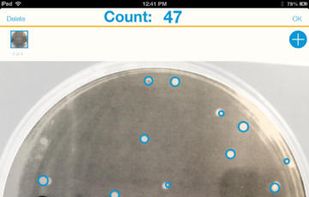
Promega Colony Counter screenshot 3

Is the tedium of squinting over agar plates counting bacterial colonies getting to you? Take the plates out of the lab! No, not literally. Snap a picture with your phone and you can make counting an out-of-lab experience.
Cost / License
- Free
- Proprietary
Platforms
- iPhone
- iPad